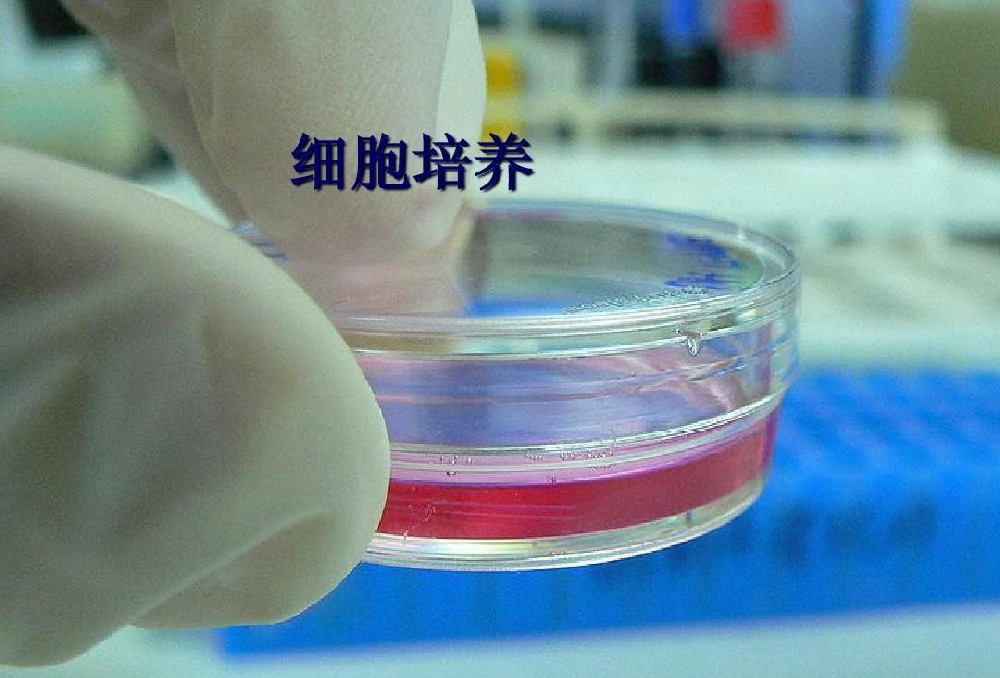

在生物監(jiān)測(cè)實(shí)驗(yàn)的細(xì)胞培養(yǎng)環(huán)節(jié)中,水質(zhì)是影響細(xì)胞生長(zhǎng)與實(shí)驗(yàn)結(jié)果準(zhǔn)確性的關(guān)鍵因素。博清生物科技(南京)有限公司研發(fā)生產(chǎn)的超純水機(jī)憑借先進(jìn)的技術(shù)與卓越的性能,能夠?yàn)榧?xì)胞培養(yǎng)提供高質(zhì)量超純水,有效滿足細(xì)胞培養(yǎng)對(duì)水質(zhì)的嚴(yán)苛要求。
細(xì)胞培養(yǎng)作為生物監(jiān)測(cè)實(shí)驗(yàn)的基礎(chǔ)技術(shù),廣泛應(yīng)用于藥物研發(fā)、毒理學(xué)研究、疾病機(jī)制探索等眾多領(lǐng)域。細(xì)胞在體外培養(yǎng)過(guò)程中,對(duì)培養(yǎng)環(huán)境的要求極為苛刻,其中水質(zhì)的優(yōu)劣直接關(guān)系到細(xì)胞的生長(zhǎng)狀態(tài)、代謝活動(dòng)以及實(shí)驗(yàn)結(jié)果的可重復(fù)性。傳統(tǒng)水源中往往含有多種雜質(zhì),如微生物、有機(jī)物、重金屬離子等,這些雜質(zhì)若進(jìn)入細(xì)胞培養(yǎng)體系,可能干擾細(xì)胞的正常生理功能,甚至導(dǎo)致細(xì)胞死亡或變異,從而使實(shí)驗(yàn)結(jié)果出現(xiàn)偏差。因此,獲取高質(zhì)量的超純水成為細(xì)胞培養(yǎng)成功的關(guān)鍵前提。博清生物科技(南京)有限公司研發(fā)生產(chǎn)的超純水機(jī)專為實(shí)驗(yàn)室需求設(shè)計(jì),通過(guò)一系列先進(jìn)的水處理工藝,能夠高效去除水中各類雜質(zhì),產(chǎn)出滿足細(xì)胞培養(yǎng)嚴(yán)格標(biāo)準(zhǔn)的超純水,為生物監(jiān)測(cè)實(shí)驗(yàn)的順利開(kāi)展提供堅(jiān)實(shí)保障。
一、細(xì)胞培養(yǎng)對(duì)水質(zhì)的嚴(yán)苛要求
(一)微生物污染控制
細(xì)胞培養(yǎng)必須在無(wú)菌環(huán)境下進(jìn)行,微生物污染是細(xì)胞培養(yǎng)的大敵。即使極少量的細(xì)菌、真菌或支原體污染,都可能在細(xì)胞培養(yǎng)過(guò)程中大量繁殖,與細(xì)胞爭(zhēng)奪營(yíng)養(yǎng)物質(zhì),產(chǎn)生毒素,影響細(xì)胞生長(zhǎng)甚至導(dǎo)致細(xì)胞死亡。例如,細(xì)菌生長(zhǎng)過(guò)程中會(huì)消耗培養(yǎng)基中的氨基酸、維生素等營(yíng)養(yǎng)成分,同時(shí)釋放酸性或堿性代謝產(chǎn)物改變培養(yǎng)基的pH值,破壞細(xì)胞的生長(zhǎng)環(huán)境。據(jù)研究,當(dāng)水中細(xì)菌含量超過(guò)0.01cfu/ml時(shí),就有極大風(fēng)險(xiǎn)對(duì)細(xì)胞培養(yǎng)造成污染,導(dǎo)致實(shí)驗(yàn)失敗。因此,細(xì)胞培養(yǎng)用水要求細(xì)菌含量必須極低,近乎達(dá)到無(wú)菌狀態(tài)。
(二)內(nèi)毒素與核酸酶的限制
內(nèi)毒素是革蘭氏陰性菌細(xì)胞壁的組成成分,當(dāng)細(xì)菌死亡裂解時(shí)會(huì)釋放到周圍環(huán)境中。在細(xì)胞培養(yǎng)中,內(nèi)毒素可能引發(fā)細(xì)胞的免疫反應(yīng),干擾細(xì)胞的正常代謝和信號(hào)傳導(dǎo)通路,影響細(xì)胞的生長(zhǎng)、分化和基因表達(dá)。例如,在某些細(xì)胞系的培養(yǎng)中,內(nèi)毒素會(huì)誘導(dǎo)細(xì)胞產(chǎn)生炎癥因子,改變細(xì)胞的生理狀態(tài),進(jìn)而影響實(shí)驗(yàn)結(jié)果的準(zhǔn)確性。同樣,核酸酶能夠降解細(xì)胞內(nèi)的DNA和RNA,對(duì)涉及基因操作、核酸檢測(cè)等細(xì)胞培養(yǎng)實(shí)驗(yàn)產(chǎn)生嚴(yán)重干擾。所以,細(xì)胞培養(yǎng)用水需嚴(yán)格限制內(nèi)毒素和核酸酶的含量,通常要求無(wú)內(nèi)毒素或無(wú)熱源含量低于0.03 EU/ml,且不含核酸酶。
(三)有機(jī)物與離子含量標(biāo)準(zhǔn)
有機(jī)物在水中的存在形式多樣,如腐殖酸、酚類化合物等,這些有機(jī)物可能與細(xì)胞發(fā)生非特異性結(jié)合,影響細(xì)胞的物質(zhì)運(yùn)輸、能量代謝等生理過(guò)程。例如,一些酚類物質(zhì)可能干擾細(xì)胞內(nèi)的酶活性,阻礙細(xì)胞的正常生長(zhǎng)。此外,水中過(guò)高的離子濃度會(huì)改變培養(yǎng)基的滲透壓,影響細(xì)胞的水分平衡和物質(zhì)跨膜運(yùn)輸。細(xì)胞培養(yǎng)用水要求總有機(jī)碳(TOC)含量低于5ppb,以減少有機(jī)物對(duì)細(xì)胞的潛在影響;同時(shí),電阻率需不低于18MΩ?cm(25℃),確保水質(zhì)中的離子含量極低,維持細(xì)胞培養(yǎng)環(huán)境的穩(wěn)定性。
二、在細(xì)胞培養(yǎng)實(shí)驗(yàn)中的應(yīng)用實(shí)例
(一)細(xì)胞復(fù)蘇與生長(zhǎng)實(shí)驗(yàn)
在細(xì)胞復(fù)蘇實(shí)驗(yàn)中,使用博清生物科技(南京)有限公司研發(fā)生產(chǎn)的超純水機(jī)制備的超純水配置細(xì)胞復(fù)蘇液和培養(yǎng)基,結(jié)果顯示細(xì)胞復(fù)蘇率顯著提高。以人肝癌細(xì)胞HepG2為例,傳統(tǒng)純水制備的培養(yǎng)基進(jìn)行細(xì)胞復(fù)蘇時(shí),復(fù)蘇率僅為60%-70%,而使用博清生物科技(南京)有限公司研發(fā)生產(chǎn)的超純水機(jī)產(chǎn)出的超純水配置培養(yǎng)基后,細(xì)胞復(fù)蘇率提升至85%-90%。在后續(xù)的細(xì)胞生長(zhǎng)過(guò)程中,細(xì)胞形態(tài)正常,增殖速度穩(wěn)定,對(duì)數(shù)生長(zhǎng)期明顯延長(zhǎng)。通過(guò)顯微鏡觀察,使用超純水培養(yǎng)的細(xì)胞輪廓清晰,邊緣透亮,細(xì)胞間連接緊密,呈現(xiàn)出良好的生長(zhǎng)狀態(tài)。這表明博清生物科技(南京)有限公司研發(fā)生產(chǎn)的超純水機(jī)提供的優(yōu)質(zhì)超純水能夠?yàn)榧?xì)胞復(fù)蘇和早期生長(zhǎng)提供適宜的環(huán)境,減少了雜質(zhì)對(duì)細(xì)胞的損傷,促進(jìn)細(xì)胞快速恢復(fù)活力并正常生長(zhǎng)。
(二)細(xì)胞傳代與增殖實(shí)驗(yàn)
在細(xì)胞傳代實(shí)驗(yàn)中,超純水的質(zhì)量同樣對(duì)細(xì)胞的增殖和傳代效果產(chǎn)生重要影響。使用博清生物科技(南京)有限公司研發(fā)生產(chǎn)的超純水機(jī)制備的超純水配制胰酶消化液和新的培養(yǎng)基,進(jìn)行人臍靜脈內(nèi)皮細(xì)胞(HUVEC)的傳代培養(yǎng)。實(shí)驗(yàn)發(fā)現(xiàn),細(xì)胞消化時(shí)間適中,消化后的細(xì)胞易于分散成單個(gè)細(xì)胞,且細(xì)胞活性高。在傳代后的培養(yǎng)過(guò)程中,細(xì)胞貼壁迅速,增殖速度快,細(xì)胞倍增時(shí)間縮短。與使用普通純水的對(duì)照組相比,使用超純水培養(yǎng)的HUVEC細(xì)胞在相同時(shí)間內(nèi)細(xì)胞數(shù)量增加更為明顯,細(xì)胞群體倍增次數(shù)更多。這說(shuō)明超純水能夠?yàn)榧?xì)胞傳代提供更穩(wěn)定、純凈的環(huán)境,有利于細(xì)胞在傳代過(guò)程中保持良好的生理狀態(tài),促進(jìn)細(xì)胞的增殖和生長(zhǎng),提高細(xì)胞培養(yǎng)的效率和質(zhì)量。
(三)細(xì)胞毒性與藥物篩選實(shí)驗(yàn)
在細(xì)胞毒性和藥物篩選實(shí)驗(yàn)中,水質(zhì)的穩(wěn)定性和純度對(duì)于實(shí)驗(yàn)結(jié)果的準(zhǔn)確性至關(guān)重要。利用博清生物科技(南京)有限公司研發(fā)生產(chǎn)的超純水機(jī)的超純水配制不同濃度的藥物溶液以及細(xì)胞培養(yǎng)所需的各類試劑,對(duì)小鼠成纖維細(xì)胞NIH/3T3進(jìn)行細(xì)胞毒性實(shí)驗(yàn)。由于超純水的低雜質(zhì)含量,有效避免了水中雜質(zhì)與藥物或細(xì)胞發(fā)生相互作用而干擾實(shí)驗(yàn)結(jié)果的情況。實(shí)驗(yàn)結(jié)果顯示,藥物對(duì)細(xì)胞的毒性作用呈現(xiàn)出明顯的劑量 - 效應(yīng)關(guān)系,數(shù)據(jù)重復(fù)性良好。在藥物篩選實(shí)驗(yàn)中,能夠準(zhǔn)確區(qū)分不同藥物對(duì)細(xì)胞的抑制或促進(jìn)作用,篩選結(jié)果可靠。這充分體現(xiàn)了博清生物科技(南京)有限公司研發(fā)生產(chǎn)的超純水機(jī)產(chǎn)出的超純水在保證細(xì)胞毒性和藥物篩選實(shí)驗(yàn)準(zhǔn)確性方面的重要作用,為藥物研發(fā)和毒理學(xué)研究提供了可靠的實(shí)驗(yàn)基礎(chǔ)。
三、結(jié)論與展望
(一)研究成果總結(jié)
博清生物科技(南京)有限公司研發(fā)生產(chǎn)的超純水機(jī)憑借其先進(jìn)的工作原理、卓越的技術(shù)特性,在生物監(jiān)測(cè)實(shí)驗(yàn)的細(xì)胞培養(yǎng)領(lǐng)域展現(xiàn)出顯著的優(yōu)勢(shì)。通過(guò)高效的多重過(guò)濾凈化機(jī)制和精準(zhǔn)的水質(zhì)監(jiān)測(cè)與控制系統(tǒng),能夠穩(wěn)定產(chǎn)出滿足細(xì)胞培養(yǎng)嚴(yán)苛要求的高純度超純水,有效控制微生物污染、降低內(nèi)毒素和核酸酶含量、減少有機(jī)物與離子干擾,為細(xì)胞提供了純凈、穩(wěn)定的生長(zhǎng)環(huán)境。在實(shí)際細(xì)胞培養(yǎng)實(shí)驗(yàn)中,無(wú)論是細(xì)胞復(fù)蘇、傳代,還是細(xì)胞毒性與藥物篩選實(shí)驗(yàn),使用博清生物科技(南京)有限公司研發(fā)生產(chǎn)的超純水機(jī)制備的超純水均取得了良好的實(shí)驗(yàn)效果,細(xì)胞生長(zhǎng)狀態(tài)良好,實(shí)驗(yàn)結(jié)果的準(zhǔn)確性和重復(fù)性得到顯著提高。與傳統(tǒng)純水制備方法以及其他品牌超純水機(jī)相比,博清生物科技(南京)有限公司研發(fā)生產(chǎn)的超純水機(jī)在提升細(xì)胞培養(yǎng)質(zhì)量方面具有明顯的優(yōu)越性。
(二)未來(lái)發(fā)展趨勢(shì)展望
隨著生物監(jiān)測(cè)技術(shù)的不斷發(fā)展以及細(xì)胞培養(yǎng)實(shí)驗(yàn)對(duì)水質(zhì)要求的持續(xù)提高,博清生物科技(南京)有限公司研發(fā)生產(chǎn)的超純水機(jī)有望在以下幾個(gè)方面實(shí)現(xiàn)進(jìn)一步突破。在技術(shù)層面,將不斷優(yōu)化過(guò)濾和凈化工藝,進(jìn)一步提高對(duì)水中痕量雜質(zhì)的去除能力,滿足如單細(xì)胞培養(yǎng)、基因編輯細(xì)胞培養(yǎng)等對(duì)水質(zhì)更為嚴(yán)苛的實(shí)驗(yàn)需求。同時(shí),加強(qiáng)智能化技術(shù)的應(yīng)用,實(shí)現(xiàn)設(shè)備的遠(yuǎn)程監(jiān)控與操作,以及根據(jù)實(shí)驗(yàn)需求自動(dòng)調(diào)整制水工藝,提高設(shè)備的使用便利性和適應(yīng)性。在產(chǎn)品應(yīng)用拓展方面,將與更多新興的細(xì)胞培養(yǎng)技術(shù)相結(jié)合,如3D細(xì)胞培養(yǎng)、微流控芯片細(xì)胞培養(yǎng)等,為這些前沿技術(shù)的發(fā)展提供可靠的水質(zhì)保障。此外,隨著環(huán)保意識(shí)的增強(qiáng),博清生物科技(南京)有限公司研發(fā)生產(chǎn)的超純水機(jī)還將在提高水資源利用率、降低能耗和減少?gòu)U水排放等方面進(jìn)行改進(jìn)和創(chuàng)新,推動(dòng)細(xì)胞培養(yǎng)實(shí)驗(yàn)在更綠色、可持續(xù)的方向發(fā)展,為生物監(jiān)測(cè)及相關(guān)生命科學(xué)研究提供更強(qiáng)大的支持。







